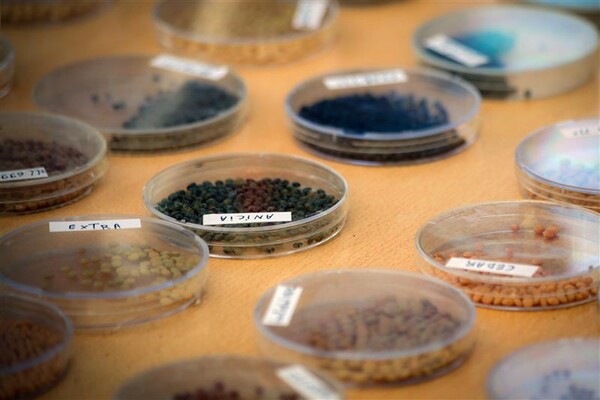
Seedds Morocco

Women Scientists at the Heart of Genetic Diversity Conservation

ICARDA’s seed collections carry adaptive traits developed over generations, including tolerance to drought, poor soils, and high temperatures. In dry regions facing compounded climate and socio-economic pressures, this genetic diversity is critical to sustaining agricultural productivity and rural livelihoods. Maintaining their value over time relies on the scientists and the systems they set up to conserve, document, and make this diversity accessible for use.
On the International Day of Women and Girls in Science, ICARDA highlights the contributions of women scientists across our genebanks in Lebanon and Morocco, where plant genetic resources are safeguarded for research and breeding across the drylands and beyond.
Inside ICARDA’s Genebanks

At times perceived only as storage facilities, genebanks are anything but static. ICARDA’s seed collections are among the largest and most diverse in the region, representing crops and their wild relatives gathered over decades of fieldwork and research. Each accession is conserved in accordance with international standards, carefully documented, and shared with researchers and breeders worldwide. Safety duplication across multiple locations, including at The Svalbard Global Seed Vault, ensures that this diversity is protected against loss, whether from climate shocks, conflict, or time itself.
Leadership and Knowledge Transfer in Genebanks

For Mariana Yazbek, Genebank Manager at ICARDA, continuity is central to the job. Her role is not only to safeguard genetic diversity, but also to ensure that the expertise required to do so does not disappear with one generation.
“Genebank work depends on accumulated knowledge,” she explains. “If that knowledge isn’t transferred, you don’t just lose experience, you introduce risk.” Many members of her team are early in their careers, bringing different academic backgrounds and areas of specialization. That mix, she believes, is essential. “It creates continuity between generations,” she adds, “where experience and institutional knowledge are passed on, while new team members bring curiosity and fresh perspectives.” Her leadership approach emphasizes responsibility and trust. “Learning by doing is essential in this field,” she says. “Over time, people begin to see how careful decisions protect material that has taken decades to build.”
According to her, those who choose to research genetic resources rarely do so by accident. There is often an immediate, shared understanding of why the work matters, and that shared purpose shapes the team's culture.
The Long Arc of Impact

That sense of continuity is also deeply familiar to Rama Jawad, Research Associate at ICARDA’s Genebank in Lebanon, who has spent over a decade working with seed collections.
When she first joined ICARDA’s genetic resources team in Lebanon, straight after graduating, the organization was in the process of retrieving much of its collection from the Svalbard Global Seed Vault to rebuild the genebanks in Lebanon and Morocco. Handling the material exposed her to a rich diversity of crops and wild species. “It really broadened my perspective,” she recalls.
Years later, Rama found herself preparing the same regenerated materials to be sent back to Svalbard for long-term safety duplication. “It was one of the most meaningful moments in my career,” she says. “Seeing the same genetic resources move through the full conservation cycle made the long-term value of genebank work very real to me.”
Beyond Storage

In Morocco, Oumaima Zaher, a Research Assistant in seed science and genetic resource conservation, brings the same care and curiosity to the work of understanding and preserving seeds at the genebank. Her role focuses on seed conservation for long-term viability by carefully managing material from field receipt through packaging, tracking, and ongoing monitoring.
But conservation, she explains, is only part of the story. “Every accession has its own unique fingerprint,” she says. “For us, the work goes beyond storage. We strive to truly understand the seeds and what makes each one distinct.”
To her, working in a genebank feels like a treasure hunt. “You don’t always know the potential hidden in each accession, but the genetic diversity we conserve holds enormous promise.”
Driven by this motivation, Omaima aims to understand seeds in all their complexity, from how they are conserved to how they can be used more effectively. Her goal is to become a seed scientist with a wide, integrated understanding of genetic resources.
The Role of Data in Genetic Resources Conservation

For Celine Sayde, Research Assistant, genetic resources work is defined by data, which is the foundation that determines whether seed collections can actually be used. Her work focuses on data curation across the genebank, ensuring that each accession is accurately documented, traceable across systems, and consistent over time. “If the data is wrong or incomplete, the material itself loses value,” she explains. “Breeders and researchers rely on that information to make decisions.”
Celine’s interest in science developed early. “I simply loved science. It never felt like a burden to me, more like a hobby than work,” she says. “As a child, I wanted to help people, and after completing my studies, I knew I wanted to use science in a practical way that directly benefits others.”
What she values most about ICARDA is its focus on long-term conservation, which allows her to apply science beyond immediate outcomes and gives her the space to build the scientific career she has envisioned. “I always wanted to help people and make a difference through science,” she says. “Being part of ICARDA allows me to do exactly that. Through this work, safeguarding genetic resources, I can contribute not only to today’s needs, but also to future food security for generations to come.” Working with crop wild relatives clarified what impact looks like in practice by translating traits such as drought, heat, and salinity tolerance into information that breeders rely on to improve crops and strengthen food security under climate change.
Carrying The Work Forward
ICARDA’s seed collections are defined not only by what they contain, but by the people who maintain them. Across genebanks, laboratories, and data systems, women scientists contribute to the long-term conservation of the region’s genetic diversity.
By investing in early-career scientists, knowledge transfer, and gender equity, ICARDA strengthens the scientific systems that ensure genetic resources research remains rigorous, relevant, and responsive to future challenges.
